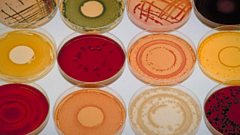

Discovery Clips
Filter by
-
![]()
How dangerous is nitrous oxide?
Duration: 03:52
-
![]()
The woman who unwittingly started the Nuclear Age
Duration: 03:50
-
![]()
The Bermuda Triangle of space
Duration: 01:14
-
![]()
Where does space begin?
Duration: 01:19
-
![]()
Why do cats get lost?—How do cats find their way home?
Duration: 01:30
-
![]()
How microbes control our weight—How much of my body is bacteria?
Duration: 01:14
-
![]()
'Extinct' Partula snails return to the wild
Duration: 02:36
-
![]()
Who won India鈥檚 first Nobel Prize?
Duration: 04:04
-
![]()
A lost civilisation revealed by 5,000-year-old weights
Duration: 03:34
-
![]()
Africa's Great Green Wall—Africa鈥檚 Great Green Wall
Duration: 03:14
-
![]()
Could the Sahel be green again?
Duration: 01:23
-
![]()
Why would someone hack your smart fridge?
Duration: 01:59
-
![]()
The clever way of growing plants in a drought
Duration: 01:45
-
![]()
Why is a Great Green Wall being built across Africa?
Duration: 00:50
-
![]()
Who invented online spam?
Duration: 03:01
-
![]()
What does the sun look like during an eclipse?
Duration: 03:17
-
![]()
Mercury鈥檚 unlikely role in treating syphilis
Duration: 02:12
-
![]()
Dying in comfort in Mongolia
Duration: 01:41
-
![]()
How do we know if a robot is conscious?
Duration: 01:53
-
![]()
Our intimate history with robots
Duration: 03:03